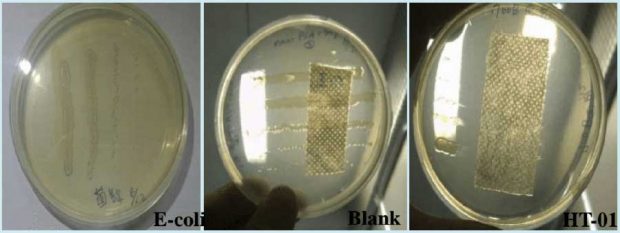
تولید ماسک جدیدی که ذرات نانو و ویروس را فیلتر می کند 2 تولید ماسک جدیدی که ذرات نانو و ویروس را فیلتر می کند

تولید ماسک جدیدی که ذرات نانو و ویروس را فیلتر می کند در دانشگاه پلی تکنیک هنگ کنگ انجام گرفته است . با استفاده از این ماسک دیگر خیالتان از بابت تنفس آلاینده ها راحت خواهد شد . برای مشاهده توضیحات بیشتر در ادامه با میهن پست همراه باشید .
شاید شما هم با خود فکر کنید تنفس با ماسکی که حتی ذراتی به اندازه یک نانو را از خود عبور نمی دهد به هیچ وجه امکان پذیر نیست چرا که ذرات نانو از مولکول های اکسیژن بسیار کوچکتر هستند .اما باید گفت والس لونگ که مدیر پروژه تولید ماسک است با همراهی دیگر دانشمندان دانشگاه پلی تکنیک هنگ کنگ توانسته با استفاده از فناوری نانو و نانو الیاف ، ماسکی تولید کند که ذرات نانو و همچنین ویروس ها را فیلتر می کند اما نسبت به اکسیژن حساس نبوده و آن را به سادگی از خود عبور می دهد .
والس لونگ شرکت آوالون نانو فایبر را در این دانشگاه تاسیس کرد و پروژه تحقیقاتی خود را روی تولید این ماسک آغاز کرد و حالا او توانسته لیسانس تولید ماسک با یک فناوری جدید را دریافت کند .
این گروه تحقیقاتی با افزایش مساحت سطحی در لایه پوششی ماسک کاری کرده اند تا نانو ذرات و ویروس ها پشت لایه پوششی فیلتر شوند اما اکسیژن به سادگی از آن عبور کند.
بصوت کلی بهترین ماسک ها امروزه با ذرات میکروالیاف نانو ساخته می شوند اما لایه ای با این الیاف نمی تواند آلودگی های ناشی از سوخت های فسیلی و یا ویروس ها را فیلتر کند اما این ماسک های جدید علاوه بر اینکه می تواند این ذرات را فیلتر کند در صورتی که به آنها نور مرئی بتابد آنتی باکتریال هم خواهد شد .
پیش از این در سال ۲۰۱۴ دانشمندان دانشگاه پلی تکنیک هنگ کنگ این ماسک را برای استفاده در کابین خودرو ها یا هواپیماها برای جلوگیری از نفوذ آلاینده ها به داخل خودرو یا هواپیما اختراع کرده بودند و حالا آن را برای استفاده های شخصی گسرتش داده اند. این طرح در نمایشگاه اختراعات ژنو در همان سال به عنوان برترین طرح شناخته شده و مدال طلا را دریافت کرده بود.
با هم در میهن پست تصاویری از پتنت ثبت شده از ماسک جدیدی که ذرات نانو و ویروس را فیلتر می کند را مشاهده می کنیم.